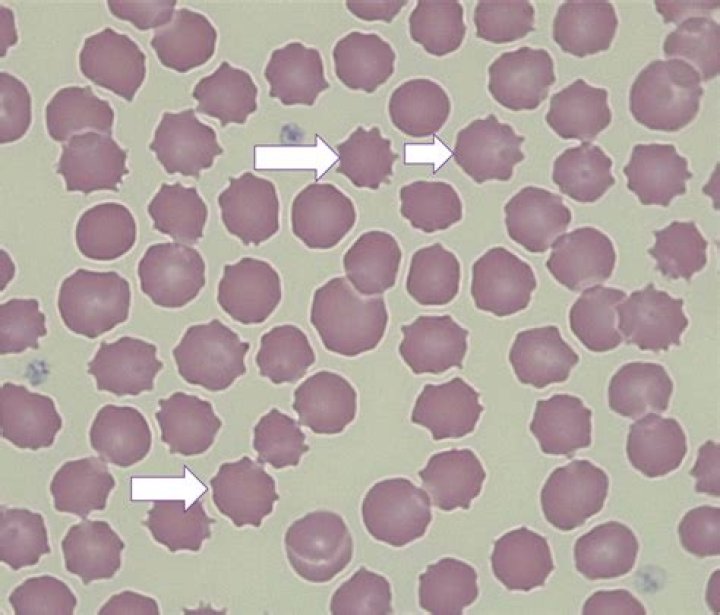

¿Qué causa la Poiquilocitosis
POIQUILOCITOS – POIQUILOCITOSIS [ICD-10: R71] Hematíes maduros de un diámetro y formas variables e irregulares que suponen más del 10% de una muestra de sangre. Esta morfología variable puede ser debida a numerosas causas como la fragmentación de los eritrocitos, daño inmunológico o anormalidades congénitas.
¿Qué es Poiquilocitosis y de dos ejemplos?
Poiquilocitosis es un término que puede aparecer en el hemograma y significa el aumento en el número de poiquilocitos circulantes en la sangre, que son hematíes que poseen una forma anormal.
¿Qué es Anisocitosis y Poiquilocitosis?
Se observa una gran variación en el tamaño (anisocitosis) y forma (poiquilocitosis) de los eritrocitos, variación que va desde células “gigantes” con cambios de morfología, ma- croesferocito, hasta eritrocitos normales pero pequeños, microcitos.
¿Qué son los Excentrocitos?
Excentrocitos: Son hematíes con distribución irregular de la hemoglobina. Su tamaño es inferior al normal y se caracteriza por poseer contornos parcialmente arrugados, pero además se observa una distribución irregular de la hemoglobina que aparece desplegada de la parte interna hacia uno de los extremos.¿Cómo se cura la anemia Hipocromica?
- Hormonas para controlar periodos menstruales con sangrado irregularmente vasto (Progeterona).
- Medicamento para estimular la producción de glóbulos rojos.
- Transfusiones de sangre.
- Cirugía para corregir úlceras estomacales con sangrado o tumores en las vísceras.
¿Qué quiere decir Normociticos Normocromicos?
Los eritrocitos que tienen un tamaño o volumen normal (normal VCM) se denominan normocitos, Cuando el VCM es elevado, se denominan macrocitos. Cuando el VCM es bajo, se denominan microcitos. Por otra parte, los eritrocitos que tienen un contenido normal de hemoglobina (CHCM) se denominan normocrómicos.
¿Cuál es la causa de la anemia Megaloblastica?
En la anemia megaloblástica, hay una disminución de los glóbulos rojos. Las células son demasiado grandes, no están completamente desarrolladas, y tienen forma anormal. Tener muy poco ácido fólico o vitamina B-12 son causas comunes de la anemia megaloblástica.
¿Qué son los Metarrubricitos?
Metarrubricitos (precursor de la serie eritroide) en diferentes grados de maduración. Frotis normal de perro. Los glóbulos rojos de los mamíferos carecen de núcleo y tienen forma bicóncava por lo que presentan un aspecto con una zona central pálida.¿Qué es Anisocromia 1+?
Anisocromía. Consiste en una falta de uniformidad en la coloración entre unos hematíes y otros. La coexistencia de dos poblaciones de hematíes, con coloraciones distintas, se produce por ejemplo en: El inicio del tratamiento de la anemia carencial.
¿Qué es la mielofibrosis síntomas?Sensación de cansancio, debilidad o dificultad para respirar, generalmente por anemia. Dolor o pesadez debajo de las costillas del lado izquierdo, debido a un agrandamiento del bazo. Hematomas que se producen con facilidad. Tendencia al sangrado.
Article first time published on¿Qué son los eritrocitos?
Tipo de glóbulo sanguíneo (célula de la sangre) que se produce en la médula ósea y se encuentra en la sangre. Los eritrocitos contienen una proteína llamada hemoglobina, que transporta oxígeno desde los pulmones a todas las partes del cuerpo.
¿Qué es la Hipocromia y anisocitosis?
Hipocromía significa que los glóbulos rojos tienen menos color de lo normal al examinarlos bajo un microscopio. Esto generalmente ocurre cuando no hay suficiente cantidad del pigmento que transporta el oxígeno (hemoglobina) en dichos glóbulos rojos.
¿Cuál es la anemia más peligrosa?
Anemia aplásica. Esta anemia poco frecuente y potencialmente mortal ocurre cuando el cuerpo no produce suficientes glóbulos rojos. Las causas de la anemia aplásica incluyen infecciones, ciertos medicamentos, enfermedades autoinmunitarias y exposición a sustancias químicas tóxicas.
¿Cuál es el mejor medicamento para la anemia?
- Tomar suplementos de hierro, vitamina B12 o ácido fólico.
- Medicamentos que inhiban el sistema inmunitario.
- Eritropoyetina, para ayudar a la médula ósea a fabricar más células sanguíneas.
- Transfusiones de sangre.
¿Que no se debe comer cuando se tiene anemia?
Leche y lácteos: Leche condensada, lácteos enriquecidos con nata o chocolate, quesos grasos. Carnes y derivados: Carnes muy grasas, vísceras (salvo el hígado), charcutería. Cereales: Bollería convencional, productos de pastelería y repostería. Bebidas: Bebidas alcohólicas.
¿Cuáles son las causas de anemia?
- Deficiencia de hierro.
- Deficiencia de vitamina B12.
- Deficiencia de folato.
- Ciertos medicamentos.
- Destrucción de los glóbulos rojos antes de lo normal (lo cual puede ser causado por problemas con el sistema inmunitario)
¿Qué vitamina produce anemia?
La anemia por deficiencia de vitaminas puede ocurrir si no comes suficientes alimentos que contengan folato, vitamina B-12 o vitamina C, o si tu cuerpo tiene problemas para absorber o procesar estas vitaminas.
¿Cómo se trata la anemia megaloblástica?
En el tratamiento de la anemia megaloblástica por déficit de folatos, además de la corrección de la dieta, se recomienda el tratamiento con suplementos farmacológicos de ácido fólico por vía oral a dosis de 5 a 10 mg/día y de 15 mg/ día ácido folínico hasta la normalización hematológica y la comprobación de niveles …
¿Qué pasa cuando los leucocitos están altos en la sangre?
El recuento de glóbulos blancos alto (leucocitosis) significa que hay demasiados leucocitos circulando por la sangre, por lo general, debido a una infección. Una variedad de enfermedades y trastornos diferentes pueden provocar un recuento de glóbulos blancos alto a largo plazo.
¿Cuánto es lo normal de linfocitos en una mujer?
Linfocitos: Valor normal entre 1000 y 4500/mL. Aumentan sobre todo en infecciones por virus o parásitos. También en algunos tumores o leucemias. Monocitos: Valor normal entre 200 y 800/mL.
¿Qué son los Macrocitos y cómo se conforman?
“Macrocitosis” es un término que se utiliza para describir los glóbulos rojos que tienen un tamaño mayor que lo normal. En general, esta afección, también conocida como megalocitosis, no produce signos ni síntomas, y se suele detectar incidentalmente en análisis de sangre de rutina.
¿Cómo se cura la anisocitosis?
Si es una anisocitosis causada por anemia no complicada, puede ser tratada con suplementos de hierro. Si se determina que es por falta de vitaminas se le dará el aporte necesario de estos nutrientes y si fuese por otro tipo de anemia, entonces el tratamiento será más complejo y de por vida.
¿Cuáles son los valores de anemia?
- Hombres adultos: 13 g/dl.
- Mujeres adultas: 12 g/dl.
- Embarazadas: 11 g/dl.
¿Qué pasa si el hematocrito está bajo?
Un hematocrito más bajo que lo normal puede indicar: Un suministro insuficiente de glóbulos rojos sanos (anemia) Una gran cantidad de glóbulos blancos debido a una enfermedad de larga duración, una infección o un trastorno en los glóbulos blancos como leucemia o linfoma. Vitaminas o minerales deficientes.
¿Qué es Chcm en perros?
CHCM: concentracioÌ n de hemoglobina corpuscular media. Es el peso de la hemoglobina en relacioÌ n al volumen eritrocitario. Se calcula mediante la foÌ rmula hemoglobina/hematoÌ crito. Valores de referencia: caninos y felinos 30-35 g/100 ml.
¿Qué son los Acantocitos en perros?
Los acantocitos, que son células de aspecto parecido a los equinocitos pero tienen una morfología más similar a un eritrocito normal. … En el caso del perro, estas células diana se han asociado con enfermedades hepáticas y con hipercolesterolemia secundaria a hipotiroidismo.
¿Qué significa Rouleaux en perros?
La formación en rouleaux (rollos) es la asociación espontánea de los eritrocitos en pilas lineales, semejando pilas de monedas. Una marcada formación en rouleaux es normal en sangre de caballo, y en menor proporción en perros y gatos normales.
¿Cómo se cura la mielofibrosis?
- Terapia dirigida con medicamentos. …
- Quimioterapia. …
- Extracción quirúrgica del bazo (esplenectomía). …
- Radioterapia.
¿Cuánto tiempo de vida tiene una persona con mielofibrosis?
Todavía se considera una enfermedad rara, que suele aparecer principalmente entre los 60 y 70 años. Los estudios muestran que los pacientes con mielofibrosis tienen una esperanza de vida reducida, con una supervivencia mediana de 5,7 años.
¿Cuánto dura una persona con mielofibrosis?
La mielofibrosis es una enfermedad muy heterogénea a nivel clínico que requiere un tratamiento individualizado ajustado al riesgo. Algunas personas pueden vivir sin síntomas durante muchos años. Otras, en cambio, pueden tener una enfermedad agresiva desde el principio o que empeora de forma progresiva.
¿Qué son los eritrocitos positivos?
Los glóbulos rojos (eritrocitos) pueden ser un signo de enfermedad renal, trastorno en la sangre u otra enfermedad subyacente, como cáncer de vejiga. Las bacterias, las levaduras o los parásitos pueden indicar una infección. Los cilindros (proteínas con forma de tubo) pueden ser el resultado de trastornos renales.



